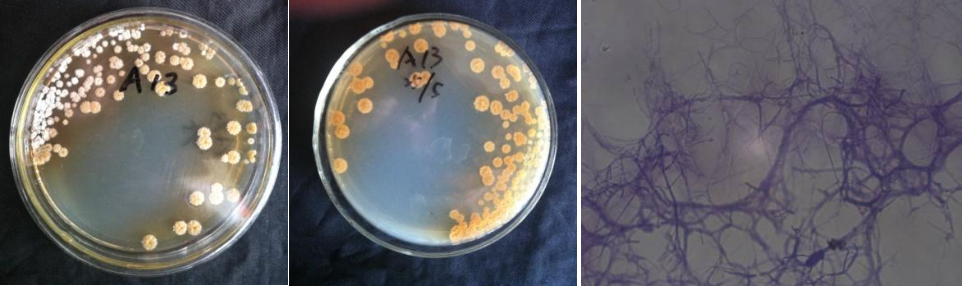

Loading...
| StrainNO | A13 |
| Classification | Streptacidiphilus |
| 16s rDNA sequence | ATGGAACAGCCAGTCGAACGATGAACCCGCTTCGGTGGGGGATTAGTGGCGAACGGGTGAGTAACACGTGGGCAATCTGCCCTTC ACTCTGGGACAAGCCCTGGAAACGGGGTCTAATACCGGATAACACCGGCCTTCGCATGGGGGCTGGTTGAAAGCTCCGGCGGTGA AGGATGAGCCCGCGGCCTATCAGCTTGTTGGTGGGGTGATGGCCTACCAAGGCGACGACGGGTAGCCGGCCTGAGAGGGCGACCG GCCACACTGGGACTGAGACACGGCCCAGACTCCTACGGGAGGCAGCAGTGGGGAATATTGCACAATGGGCGAAAGCCTGATGCAG CGACGCCGCGTGAGGGATGACGGCCTTCGGGTTGTAAACCTCTTTCAGCAGGGAAGAAGCGAAAGTGACGGTACCTGCAGAAGAA GCGCCGGCTAACTACGTGCCAGCAGCCGCGGTAATACGTAGGGCGCAAGCGTTGTCCGGAATTATTGGGCGTAAAGAGCTCGTAG GCGGCTTGTCGCGTCGGATGTGAAAGCCCGGGGCTTAACCCCGGGTCTGCATTCGATACGGGCAGGCTAGAGTGTGGTAGGGGAG ATCGGAATTCCTGGTGTAGCGGTGAAATGCGCAGATATCAGGAGGAACACCGGTGGCGAAGGCGGATCTCTGGGCCATTACTGAC GCTGAGGAGCGAAAGCGTGGGGAGCGAACAGGATTAGATACCCTGGTAGTCCACGCCGTAAACGTTGGGAACTAGGTGTTGGCGA CATTCCACGTCGTCGGTGCCGCAGCTAACGCATTAAGTTCCCCGCCTGGGGAGTACGGCCGCAAGGCTAAAACTCAAAGGAATTG ACGGGGGCCCGCACAAGCAGCGGAGCATGTGGCTTAATTCGACGCAACGCGAAGAACCTTACCAAGGCTTGACATACACCGGAAA CGGCCAGAGATGGTCGCCCCCTTGTGGTCGGTGTACAGGTGGTGCATGGCTGTCGTCAGCTCGTGTCGTGAGATGTTGGGTTAAG TCCCGCAACGAGCGCAACCCTTGTTCTGTGTTGCCAGCATGCCCTTCGGGGTGATGGGGACTCACAGGAGACTGCCGGGGTCAAC TCGGAGGAAGGTGGGGACGACGTCAAGTCATCATGCCCCTTATGTCTTGGGCTGCACACGTGCTACAATGGCCGGTACAAAGAGC TGCGATGCCGTGAGGCGGAGCGAATCTCAAAAAGCCGGTCTCAGTTCGGATTGGGGTCTGCAACTCGACCCCATGAAGTCGGAGT TGCTAGTAATCGCAGATCAGCATTGCTGCGGTGAATACGTTCCCGGGCCTTGTACACACCGCCCGTCACGTCACGAAAGTCGGTA ACACCCGAAGCCGGTGGCCCAACCCCTTGTGGGAGGGAGCTGTCGAAGGTGGGACTGGCGACCGTGCGATTCTCT |
| Strain Morphology Photos | |
| Morphological Description | Mycelia branching;septum;not broken;multi strands;short spore chain;long a grenade like bundle on the stalk;separated;broken spore pile bald type;front back ivory yellow |